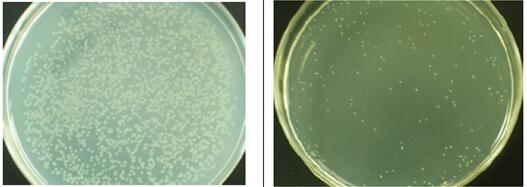
常态转化液使用效果

相关产品推荐更多 >
万千商家帮你免费找货
0 人在求购买到急需产品
- 详细信息
- 文献和实验
- 技术资料
- 保存条件:
低温运输
- 保质期:
长期
- 英文名:
Tranzol
- 库存:
434
- 供应商:
北京百奥莱博科技有限公司
特别声明:本产品及我公司所售其他产品均为科研类试剂产品,严禁用于药物、医疗及其他非科研用途。
常态细胞转化液(免感受态细胞制备)库存是高品质的克隆与表达产品,由北京百奥莱博供应,用于科研实验,本产品质量好,且极具价格优势,深为用户称道,了解更多常态细胞转化液(免感受态细胞制备)等克隆与表达产品请联系我司咨询订购。
名称:常态细胞转化液(免感受态细胞制备)库存
规格:20次
英文名:Tranzol
编号:BTN51101
本品能使各种常态的E.coli细胞直接用于快速转化实验,使广大用户不再因为简单的转化实验而再为感受态细胞的制备,保存和运输等繁琐的事情而操心,大大地缩短了基因克隆实验的时间,提高使用者的工作效率。
产品特点:
1. 不需专门制备感受态细胞,直接使用常态的细胞进行质粒转化,随用随配,十分方便。
2. 常态细胞包括新鲜培养的菌液,新鲜的或4℃放置数月的培养基菌落,甘油菌种保存液等。
3.适用菌种和质粒广泛,用过的E.coli菌种包括K12 系的DH5a和Tg1,B 系的BL21(DE3)。用过的质粒有pGEM,pET和Clion系列等。
4.转化效率适中,使用10ng质粒转化一般能得到上万个转化子)效率在10E5 到10E6 CFU/ug质粒之间),使用3-5μL连接液转化一般能得几千个转化子,足够筛选重组子使用(但不适合构建文库)。
5. 单管快速操作,整个操作可以在一个1.5mL塑料离心管中进行,最短可以在三十分钟内完成,不需要过夜细菌培养,热休克处理甚至恒温摇床,极其适用于自动化的大规模克隆筛选工作。
6. 稳定性好,本可以在-20℃条件下长期保存而不用担心转化效率的降低,而感受态细胞在同样条件下会迅速失去活性。
| 成分 | 规格 |
| 常态转化液 | 1ml |
| 阳性对照(pGEM3或pUC19)10μL,1ng/μL | 5T |
| 说明书 | 1份 |
储存条件:低温运输,-20℃保存,有效期一年。
使用方法:
1. 标记无菌的1.5mL塑料离心管并加入1mL液体培养基(如SOC或LB),每次转化试验最好加上阳性对照(用提供的pGEM3或其他质粒)和阴性对照(不加DNA)各一个。
2. 如果使用E.coli菌落,则直接用接种环,无菌牙签或无菌吸头从培养皿上挑取1-5个菌落(直径在3-5 mm之间)到每个离心管中,用移液枪轻柔吹打散开。如果使用甘油菌种保存液,则直接取50-100μl菌种液到1mL培养液中。如果使用单个菌落培养得到的新鲜培养液,则取1mL培养了3-4小时的菌液直接从第4步开始。
3. 37℃保温1小时(如果保温时间延长到3-4小时,可以提高转化效率一倍,但过长则转化效率又开始降低)。
4.室温10000rpm离心1分钟后小心移弃上清(液体培养基),离心速度低于10000rpm则细菌沉淀易丢失。沉淀的细菌约芝麻或麦片大小为宜。细胞过多或过少都不好。
5. 短暂离心,用移液枪小心将残留的培养液(约50μl)吸出,否则残留培养基将会严重影响转化效率,故此步不能省略。
6. 加入50μl 冰浴的Clion转化液并小心将细胞吹打均匀。
7. 加DNA样品。在样品管中加入1-5μl连接反应液并轻柔吹打均匀;在阳性对照管中加入5 ng阳性质粒(没被酶切的载体,也可以使用常用的pGEM,pUC,pBR322等质粒);在阴性对照管中加入连接反应的阴性对照,如果没有则不加入任何溶液或加入1-5μl无菌水。
8. 将上述离心管置于-20℃直到液体凝固为止(一般需要20分钟到1小时),然后冰浴放置5-10分钟。
9.在每个离心管中加入1mL无抗菌素的SOC或LB培养液,混匀后置37℃水浴保温1小时以便让抗性基因表达,否则将没有转化子生长。
10. 将溶液充分吹打混匀后分别取30-200μl分别涂于含相关的抗菌素的培养盘上,剩余溶液最好留4℃待用。
11. 37℃ 16-24小时培养,阴性对照盘上不应有任何落菌,否则可以判断操作中有污染或培养基中抗菌素浓度不够。使用质粒转化的阳性对照100μl涂盘一般能有上千个菌落。连接样品转化所得菌落数将取决于连接反应效率等多种因素,100μl的涂盘一般有几十到几百个转化子。
使用效果:
左图是用10 ngClionG载体转化10个E.coli Tg1菌落后得到的转化子。右图是用3μL连接液(ClionB载体+1 Kb DNA片段,10μL反应体系)转化10个E.coli DE3菌落后37℃过夜保温得到的转化子。涂盘量均为200μL。
除常态细胞转化液(免感受态细胞制备)库存外,我公司正在打折促销以下产品:
HC0043 细胞铲子
PY02-221 改良酵母浸汁-孟加拉红肉汤 250克
ARB10371 人去唾液酸糖蛋白受体(ASGPR)Elisa定量检测 Human asialoglyco protein receptor,asgpr ELISA KIT
ARB13758 鸭γ干扰素(IFN-γ)尿液中含量检测 Duck interferon γ ,ifn-γ ELISA KIT
ARB13074 小鼠肿瘤标志物(CA724)elisa测定使用说明书 Mouse ca724 ELISA KIT
CYB163053 羊抗牛IgG-FITC
ARB11479 人胰高血糖素(GC)含量检测 Human glucagon,gc ELISA KIT
BL0878 兔抗人IgM免疫血清 0.5ml
103476-89-7 Leupeptin 亮抑酶肽
BL1303 BSA标准品(5mg/ml)
PY02-143 四环素检定琼脂 250克
ARB10331 人内脏脂肪特异性丝*酸蛋白酶抑制剂(vAspin)Elisa定量检测 Human visceral adipose-specific serine protease inhibitor,vaspin ELISA KIT
BL0874 羊抗马IgG免疫血清 0.5ml
N,N"-二琥珀酰亚胺基碳酸酯 Penicillin V potassiu*(代"m") salt 74124-79-1
F030701 BIOTIN标记小鼠抗乙肝核心抗原抗体 Monoclonal Mouse Anti-HBcAg*BIOTIN
5-腺苷二磷酸二*盐 Brilliant cresyl bulue 16178-48-6
3-(N-玛啡啉)丙磺酸*盐 o-Dianisidine dihydrochloride 71119-22-7
离子交换剂Ⅴ Zearalanone
BTN80403 RNase-free水 RNase-free Water
盐*(代"酸")洛美沙星 Trehalose anhydrous 98079-52-8
常态细胞转化液(免感受态细胞制备)库存关键词:Tranzol,常态细胞转化液,免感受态细胞制备,常态细胞转化液(免感受态细胞制备),BTN51101
·一站式平末端克隆试剂盒
编号:BTN131126
英文名称:One-Stop Blunt-ended Cloning Kit
规格:20次
基因片段用Pfu等DNA聚合酶扩增得到的产物为平末端,直接克隆比较困难。做T/A克隆时,需要在其末端添加单个碱基A。本试剂盒提供了在平端添加单个A所需的所有试剂,大大方便后续的T/A克隆及序列分析。
产品特点:
1.适用范围包括:由高保真 DNA聚合酶如 Pfu、Pwo 、DeepVent等扩增而来的PCR产物;一些限制性内切酶如 EcoRV 、SmaI等酶切产生的DNA片段;粘端DNA用DNA聚合酶补平后的片段。
2.可以在任何平末端DNA片段两端分别补上单个脱氧腺嘌呤 A,间接将PCR产物克隆到T载体上。
3. 操作快速,5分钟就可以完成 。
| 成份 | 规格 |
| ddH2O | 1mL |
| 平末端载体 | 20μl |
| 10×克隆Buffer | 0.5mL |
| 说明书 | 1份 |
储存条件:低温运输,-20℃保存,有效期一年。
使用方法:
1.在离心管中加入下列溶液:
| 成份 | 用量 |
| DNA Fragment | 10ng |
| 10× Cloning Buffer | 5μL |
| 平末端载体 | 1μL |
| ddH2O | up to 50μL |
2. 72℃保温,5分钟。
3.产物回收或者 -20℃保存备用。
常态细胞转化液(免感受态细胞制备)库存关键词:Tranzol,常态细胞转化液,免感受态细胞制备,常态细胞转化液(免感受态细胞制备),BTN51101
·中性亲和素蛋白
编号:BTN131090
英文名称:Nuetral Avidin
规格:10mg
中性亲和素蛋白是一种去糖基化形式的亲和素,因此对外源凝集素的结合降低至检测不出的水平,而对结合生物素的亲和性(Ka=1015M-1)没有任何损失。中性亲和素蛋白等电点为中性,这样可以避免非特异的结合。另外它表面的赖*酸残基让它可以被衍生或者进行蛋白标记。中性亲和素蛋白的分子量为60000,对生物素的特异结合能力大约为14μg/mg蛋白,接近理论最大活性。
产品特点:
➤相比抗组*酸抗体背景更低。
➤可进行抗体剥离和重新检测。
➤ 去糖基化,将外源凝集素结合降低至不可检测水平。
➤可在组织化学中用于生物素封闭试剂。
➤ 结合能力为11-17μg生物素/mg中性亲和素蛋白。
储存条件:低温运输,-20℃保存,有效期一年。
我公司生产供应销*(代"售")的克隆与表达产品正全系列现货促销,满分期待您的垂询选购常态细胞转化液(免感受态细胞制备)库存。
风险提示:丁香通仅作为第三方平台,为商家信息发布提供平台空间。用户咨询产品时请注意保护个人信息及财产安全,合理判断,谨慎选购商品,商家和用户对交易行为负责。对于医疗器械类产品,请先查证核实企业经营资质和医疗器械产品注册证情况。
 文献和实验
文献和实验,但涂板时只取5μl 菌液涂布于不含抗生素的LB平板上,此组正常情况下应产生大量菌落。 转化率 统计每个培养皿中的菌落数。 转化后在含抗生素的平板上长出的菌落即为转化子,根据此皿中的菌落数可计算出转化子总数和转化频率,公式如下: 转化子总数=菌落数×稀释倍数×转化反应原液总体积/涂板菌液体积 转化频率(转化子数/每mg质粒DNA)=转化子总数/质粒DNA加入量(mg) 感受态细胞总数=对照组2菌落数×稀释倍数×菌液总体积/涂板菌液体积 感受态细胞转化效率=转化子总数/感受
4℃下3000g冷冻离心5分钟; 6.弃去上清,加入 100μl预冷0.1M CaCl2 溶液,用移液枪轻轻上下吸动打匀,使细胞重新悬浮,在冰放置20分钟; 7.4℃下3000g冷冻离心5分钟; 8.弃去上清,加入 100μl预冷0.1M CaCl2 溶液,用移液枪轻轻上下吸动打匀,使细胞重新悬浮; 9.细胞悬浮液可立即用于转化实验或添加冷冻保护剂( 15% - 20%甘油)后超低温冷冻贮存备用(-70℃)。 二、电转化法制备大肠杆菌感受态细胞的实验
输注血液或血液制品均有传播疾病的危险,常见的有乙型、丙型肝炎,艾滋病,巨细胞病毒感染,梅毒,疟疾,弓形体病等。此旬,如血液被细菌污染,可使受血者由此引起菌血症,严重者可致败血症。在由输血引起的疾病中,艾滋病危害性最大。 1.肝炎:输血后肝炎的传播情况与下列因素有关:①献血者人群中肝炎流行情况;②所用的检测肝炎试验的灵敏度与特异性;③血浆制品中肝炎病毒灭活效果,近年来由于采用了比较灵敏的乙型与丙肝炎的筛选试验,传播率明显下降,但仍不能免其发生,尤其以使用混合血浆制品时可能
 技术资料
技术资料暂无技术资料 索取技术资料










